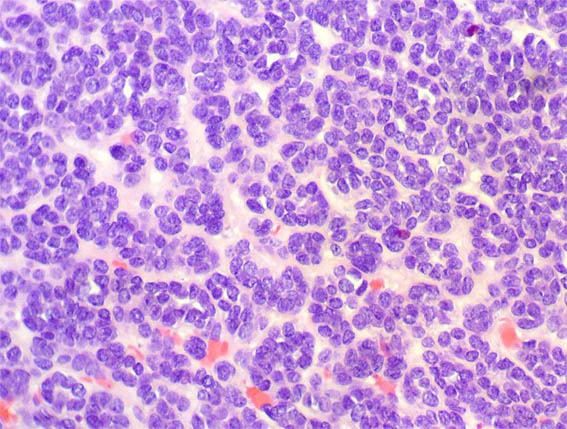
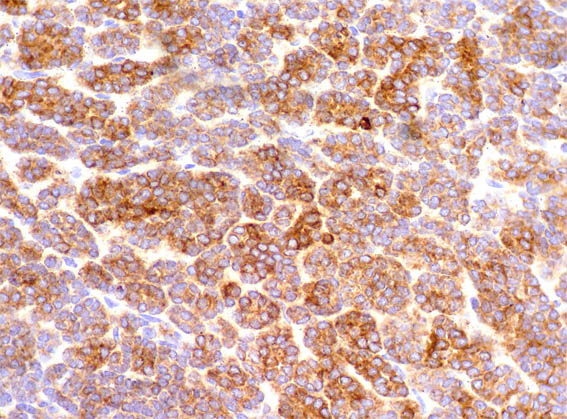

|
|
CASO
126 (Agosto de 2016)
Datos clínicos:
Mujer de 71 años. Como hallazgo incidental, en estudios de imagen por colelitiasis, detectan masa renal de 5 cm con áreas sólidas y quísticas. Hacen nefrectomía.
Observe las imágenes.

Figura 1.

Figura 2.

Figura 3.
H&E, X100.

Figura 4. H&E, X200.
Figura 5.
H&E, X400.

Figura 6. H&E, X200.

Figura 7. H&E, X100.

Figura 8. H&E, X200.

Figura 9. H&E, X400.

Figura 10. H&E, X200.
Figura 11. Inmunohistoquímica para coctel de citoqueratinas, X200.

Figura 12. Inmunohistoquímica para EMA, X400.

Figura 13. Inmunohistoquímica para WT1, X400.

Figura 13. Inmunohistoquímica para alfa-metilacil-CoA racemasa (AMACR), X400.
¿Cuál es su diagnóstico?
Ver
diagnóstico y discusión
[Arriba]
|
|